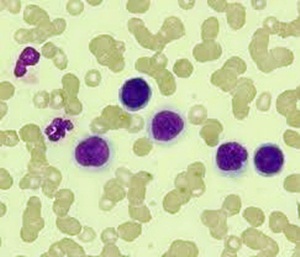

골수암 증상 치료 마음
골수는 우리 몸에 필요한 적혈구, 백혈구, 혈소판과 같은 혈액세포를 만드는 조직입니다. 골수는 겉질뼈로 둘러싸인 해면뼈조직 사이의 조혈 공간을 이야기하는데요. 골수에 이상이 생기면 치명적인 문제가 발생할 수 있습니다. 골수암에 대해 궁금하신 사항은 아래를 참조하세요.






골수암 이란?
골수암은 전문용어로 급성 골수성 백혈병이라고 말합니다. 이는 정상적인 백혈구 생산을 막는 비정상적인 세포가 골수에 생성되어 축적되는 혈액 암인데요. 주로 성인에게 발생률이 높으며 나이가 많을수록 발병률이 증가하게 됩니다.
미국 전체 사망자 중 1.2%를 차지할 정도로 희귀한 질병이라고 할 수 있습니다. 골수암의 원인은 정확하게 밝혀지지 않았습니다. 신속하게 치료하지 않고 방치하면 치명적이 될 수 있습니다. 골수암의 치료와 예후는 상당히 다양한데요. 5년 생존율은 15-70%에 달하며 재발률은 33-78%로 보고되고 있습니다.

골수암 증상
1. 다발성 골수종
골수종은 다발성 골수종 또는 형질 세포종이라고 불립니다. 골수종은 뼈에 침투하는 특징이 있고 뼈를 녹이기 때문에 골절이 잘 일어납니다. 뼛속의 칼슘이 혈액으로 녹아들기 때문에 고칼슘 혈증이 일어날 수 있습니다. 탈수와 피로, 무력감 등의 증상도 나타납니다. 이것은 골수암의 대표적인 증상으로 뼈 손실과 감염 퇴치 능력의 감소로 이어질 수 있습니다.
2. 백혈병
백혈병은 백혈구와 관련된 질병입니다. 신체는 정상적일 수 있지만 죽지 않는 비정상적인 혈액세포를 생성합니다. 이 숫자가 커지면 백혈구와 적혈구, 혈소판을 뭉쳐서 골수의 기능을 방해하게 됩니다. 처음에는 증상이 경미할 수 있지만 몇 년이 지나 증상이 생기는지 알 수는 없습니다.



3. 증상과 징후
피로와 빈혈, 출혈 및 타박상, 감염 증가, 극도의 갈증, 잦은 배뇨, 탈수증, 복통, 식용 상실, 졸음, 고칼슘 혈증, 뼈의 통증, 신장 손상, 신부전, 말초 신경 질환, 열과 오한, 체중 감소, 부종, 코피, 피부의 적색 반점, 발한, 식은땀, 발진이나 가려움.
골수암 치료
1. 화학요법
가장 흔한 치료방법으로 신체의 암세포를 파괴하는 요법입니다. 골수암의 유형에 따라 약물이나 약물 조합으로 처방됩니다.
2. 방사선 요법
표적이 되는 부위에 방사선을 노출하여 암세포를 죽이고 크기를 줄입니다. 또한 통증을 완화시킬 수 있습니다.
3. 골수 이식
다른 치료방법이 없을 때 손상된 골수를 건강한 골수로 대체시키는 방법입니다. 이 치료 과정에는 고용량의 화학 요법이나 방사선 요법이 포함되기도 합니다.
4. 생물학적 치료
우리 몸의 면역체계를 시용하여 암세포를 죽이도록 유도합니다.






골수암 생활태도
골수암은 치명적일 수 있는 희귀질환이지만 세상에는 이러한 암을 극복한 사람들도 많습니다. 미국의 한 여성 앵커는 골수암뿐만 아니라 유방암을 이겨냈습니다. 그녀는 자신에게 어떤 것이 행복하고 어떤 것이 의미 있는 것인지 정확하게 알 필요가 있다고 지적하였습니다.






또한 그녀는 자신의 투병생활을 도운 연인에게 감사를 표현했으며 공개적으로 자신이 동성애자임을 밝히기도 했습니다. 이러한 이야기는 암 조기 발견의 중요성과 암을 대하여 삶의 태도에 있다고 생각합니다.






우리는 우리 자신을 스스로 깨침으로써 자신의 병의 원인을 스스로 찾아낼 수 있게 됩니다. 이러한 깨달음은 모든 사람에게 올 수도 그렇지 않을 수도 있지만, 항상 감사하는 마음과 긍정적인 태도를 간직하면 암도 충분히 이겨낼 수 있다고 생각합니다.
오늘은 골수암에 대해 여러 가지 이야기를 살펴보았습니다. 오늘 하루도 각자의 자리에서 행복을 추구하고 감사하는 마음을 갖도록 합시다. 저 또한 읽어주신 여러분들께 감사함을 전하고 싶습니다.
댓글